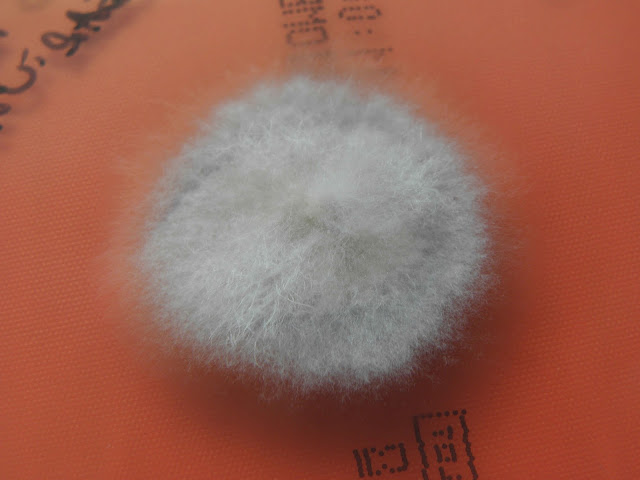

|
| Colónia com 7 dias de incubação. |
 |
| Reverso da colónia. |
 |
| Colónias com 18 dias de incubação |
 |
| Reverso da colónia. |
 |
| Hifas "reflexivas". |
 |
| Em colónias velhas podem desenvolver-se clamidósporos. |
____________________________________________________________________________
Outra estirpe (de coleção)
 |
| Colónia com 14 dias de incubação. |
 |
| Colónia com 14 dias de incubação. |
 |
| Colónia com 14 dias de incubação. |
 |
| Reverso de colónia com 14 dias de incubação. |
 |
| Colónia com 36 dias de incubação. |
 |
| Reverso de colónia com 36 dias de incubação. |
 |
| Clamidosporo. |
 |
| Clamidosporo. |
 |
| Clamidosporo. |
 |
| Clamidosporo. |
 |
| Microconideos. |